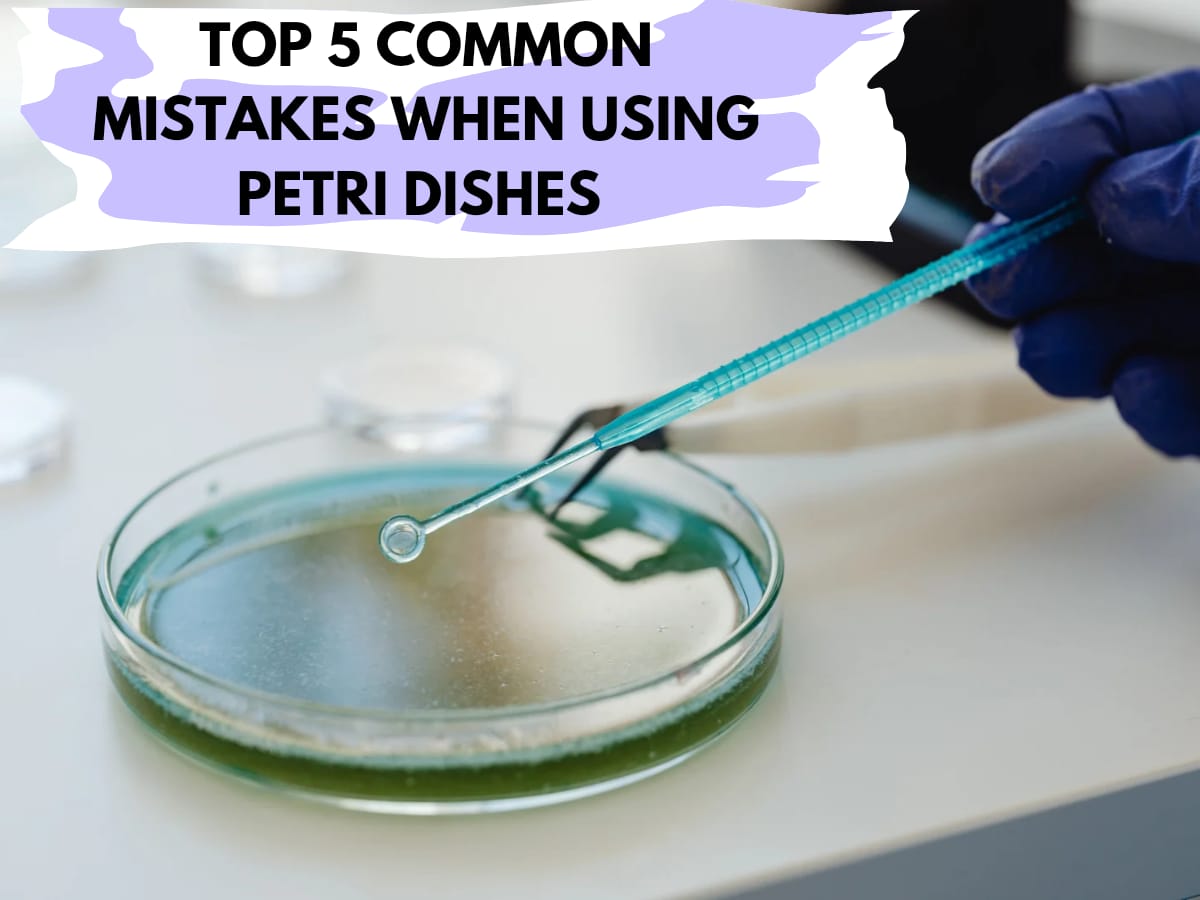
Top 5 Common Mistakes When Using Petri Dishes And How To Avoid Them

Category: Uncategorized
Why Choose Kolkata for High-Quality Laboratory Equipment ?
Introduction When it comes to sourcing high-quality Laboratory Equipment, Kolkata is emerging as a leading hub. The city, known for its rich cultural heritage, is fast becoming a focal point for scientific and industrial advancements. But what makes Kolkata a standout choice for laboratory equipment? Let’s delve into the factors that set Kolkata apart

Top 10 Chemical Importers in Guwahati in 2025
Introduction In the rapidly growing industrial landscape of Guwahati, the role of chemical importers cannot be overstated. These importers are pivotal in ensuring the continuous supply of essential chemicals that drive various industries, from pharmaceuticals to agriculture. As we step into 2025, it is crucial to recognize the top chemical importers in Guwahati who are

Top Ways Lab Equipment Distributors Fuel Innovation in Scientific Research
Innovation in scientific research is the backbone of global progress, touching everything from healthcare to environmental conservation. Yet, behind every groundbreaking discovery lies a robust support system, with Lab Equipment Distributors playing a critical role. These distributors are often the unsung heroes, ensuring that research institutions have access to the latest, high-quality equipment, expert support,

pH Paper And Litmus Paper: Which is the Most Accurate for Your Experiments?
In the realm of chemistry and biology, measuring the acidity or basicity of solutions is essential for a variety of experiments and applications. Two common tools used for this purpose are pH paper and litmus paper. While both serve as indicators of pH levels, they differ significantly in terms of accuracy, usability, and the information
Top 5 Common Mistakes When Using Petri Dishes And How To Avoid Them
Do you find it difficult to adequately streak a Petri Dishes? Then you have arrived at theright place. In this article, we will completely detail a technique known as the Four QuadrantStreak. While other approaches exist, this one assures that a colony is properly isolatedfrom a larger sample. The four quadrant approach aims to lower

The Importance of Quality Control For General Laboratory Chemicals
A crucial component of laboratory operations is quality control (QC), particularly when working with common laboratory chemicals. It guarantees that the chemicals employed in analyses and experiments adhere to strict excellence, reliability, and safety criteria. In addition to addressing its effects on accuracy, safety, regulatory compliance, customer trust, and overall laboratory efficiency, this blog article
HPLC Analysis: A Step-by-Step Guide for Beginners
High pressure is used in high performance liquid chromatography to force a liquid sample down a column that has a stationary phase inside of it. Effective chemical compound separation is made possible by this approach, which also works with tiny molecules and polymers. HPLC is used to monitor environmental pollutants, such as pesticides and heavy
Top 5 Budget-Friendly Laboratory Equipment Suppliers: Quality Without Compromise
India’s laboratory equipment manufacturing sector is is thriving . The market for laboratory equipment suppliers is proliferating by rising healthcare spending, rising public awareness of health issues, the prevalence of lifestyle diseases, and the rapidly expanding health sector. Over a five-year period, from 2019 to 2024, laboratory equipment makers are predicted to have a global

Top 10 Advance Laboratory Information Management Systems (LIMS) of 2024: A Comprehensive Review
In today’s fast-paced scientific environment, laboratories rely more on innovative technologies to expedite operations, improve data management, and maintain compliance. One such important instrument is the Laboratory Information Management System . Is a software solution that aims to centralize and manage laboratory data, workflows, and procedures. It enables laboratories to improve their efficiency, accuracy, and
Top 3 Benefits Of Partnering With A Reliable Laboratory Supplier
Scientific research’s unwavering quest of knowledge is the foundation for developments in technology, medicine, and many other sectors. All of the world’s innovations, including life-saving surgeries and innovative discoveries, are a result of the hard work and devotion of researchers. However, an important but frequently unsung partner plays a critical role in this undertaking behind